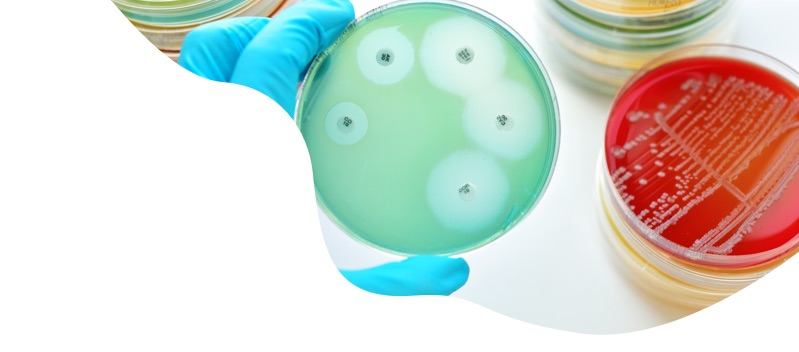
Antimicrobial resistance

Antimicrobial resistance
Antimicrobial resistance (AMR) is a serious global public health threat. It occurs when bacteria and other microorganisms change over time and develop resistance to antibiotics and other antimicrobial medicines, making them less effective. This constitutes a threat to the effective treatment of infections caused by bacteria and other microorganisms.
AMR affects both human and veterinary medicines and EMA and the European medicine regulatory network have a pivotal role in bringing those two aspects together. The global challenge posed by AMR can only be tackled by increasing coordination in the EU and worldwide to develop new treatments and tests while using the existing therapies wisely and responsibly, both in the treatment of humans and animals.
This is why AMR is one of the six strategic areas included in the ‘European medicines agencies network strategy to 2025’, which details the strategic objectives and work plans of EMA and the NCAs of the EU Member States.
In 2020, EMA contributed to the global fight against AMR by:
- supporting the development of new antimicrobial agents;
- collecting data on the consumption of veterinary antimicrobials;
- encouraging and advising on responsible use of antimicrobials.
Development of new antimicrobial agents
In 2020, four new antibacterial agents received a positive opinion from the CHMP: Fetcroja (cefiderocol) is an antibiotic used in adults to treat infections caused by certain bacteria (aerobic Gram-negative bacteria). This medicine is for use when other antibiotic treatments might not work and there are limited treatment options for patients. Xenleta (lefamulin) is an antibiotic used in adults to treat a lung infection caught outside hospital when other antibiotic medicines are not suitable or do not work. Devprela (pretomanid) is a medicine for treating adults with tuberculosis that is resistant to antibiotics. Tigecycline Accord (tigecycline) is a medicine used to treat adults and children older than eight years with complicated infections of the tissue below the skin when other antibiotics are not suitable.
Data on veterinary antibiotic consumption
The 10th annual report on the European Surveillance of Veterinary Antimicrobial Consumption (ESVAC), published by EMA in October 2020 and presenting data from 30 countries from the European Economic Area and Switzerland, shows that European countries continue to reduce the use of antibiotics in animals. The overall sales of veterinary antibiotics in European countries dropped by more than 34% between 2011 and 2018.
Also, total sales of certain veterinary antimicrobial agents belonging to antibiotic classes that are considered critically important in human medicine noticeably decreased between 2011 and 2018.
The ESVAC project was conceived and developed to support and harmonise the collection of sales data of veterinary antibiotics. The report is used by scientists, veterinarians and other health professionals, risk assessors and risk managers in Member States as a reference for antimicrobial policies and for guidance on the responsible use of antimicrobials.
Responsible use of antimicrobials
Updated categorisation of antibiotics in animals
In January 2020, EMA published its updated scientific advice on the categorisation of antibiotics. The scientific advice ranks antibiotics by considering both the risk that their use in animals causes to public health through the possible development of AMR and the need to use them in veterinary medicine. The classification comprises four categories, from A to D: Avoid (A), Restrict (B), Caution (C) and Prudence (D).
Veterinarians are encouraged to consult the infographic when deciding which antibiotic to prescribe to animals. It can also be used as a tool to draft treatment guidelines.
CATEGORISATION OF ANTIBIOTIC CLASSES FOR VETERINARY USE
(WITH EXAMPLES OF SUBSTANCES AUTHORISED FOR HUMAN OR VETERINARY USE IN THE EU)

